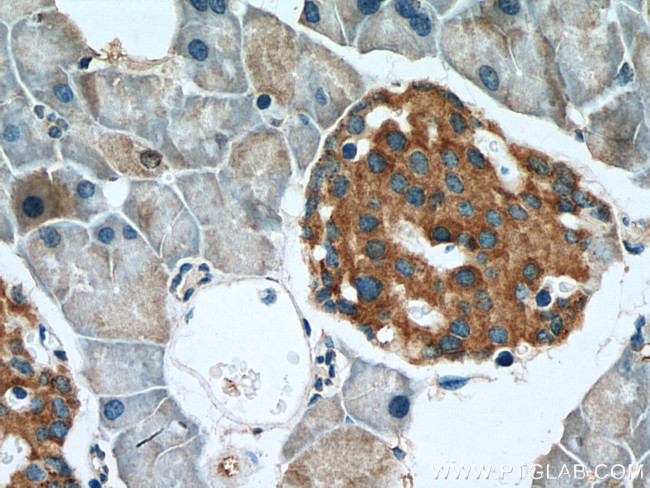
FAM3A Antibody in Immunohistochemistry (Paraffin) (IHC (P))

Search
Proteintech
FAM3A Polyclonal Antibody
{{$productOrderCtrl.translations['antibody.pdp.commerceCard.promotion.promotions']}}
{{$productOrderCtrl.translations['antibody.pdp.commerceCard.promotion.viewpromo']}}
{{$productOrderCtrl.translations['antibody.pdp.commerceCard.promotion.promocode']}}: {{promo.promoCode}} {{promo.promoTitle}} {{promo.promoDescription}}. {{$productOrderCtrl.translations['antibody.pdp.commerceCard.promotion.learnmore']}}
产品信息
20588-1-AP
种属反应
宿主/亚型
分类
类型
抗原
偶联物
形式
浓度
规格
纯化类型
保存液
内含物
保存条件
运输条件
产品详细信息
Aliquoting is unnecessary for -20°C storage.
靶标信息
A novel cytokine-like gene family using structure-based methods to search for novel four-helix-bundle cytokines in genomics databases. There are four genes in this family, FAM3A, FAM3B, FAM3C, and FAM3D, each encoding a protein (224-235 amino acids) with a hydrophobic leader sequence. Northern analysis indicates that FAM3B is highly expressed in pancreas, FAM3D in placenta, and FAM3A and FAM3C in almost all tissues. Immunohistochemistry showed that FAM3A is expressed prominently in the vascular endothelium, particularly capillaries. Fam3a staining in capillary endothelium and endocardium of heart, as well as vascular endothelial staining in many other tissues.
仅用于科研。不用于诊断过程。未经明确授权不得转售。
篇参考文献 (0)
生物信息学
蛋白别名: 2.19; Cytokine-like protein 2-19; family with sequence similarity 3 member A; Protein FAM3A; unnamed protein product
基因别名: 1810037C20Rik; 2-19; 2.19; DLD; DXS560S; FAM3A; XAP-7
UniProt ID: (Human) P98173, (Mouse) Q9D8T0
Entrez Gene ID: (Human) 60343, (Mouse) 66294